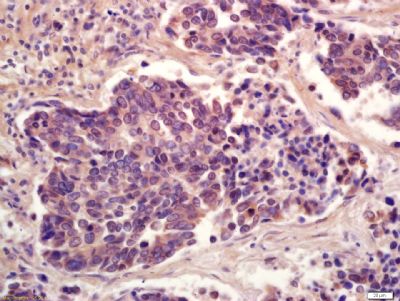
产品细节图片5

相关产品推荐更多 >
万千商家帮你免费找货
0 人在求购买到急需产品
- 详细信息
- 文献和实验
- 技术资料
- 供应商:
上海康朗生物科技有限公司
- 库存:
大量
- 目录编号:
kl-4888R
- 克隆性:
多克隆
- 抗原来源:
Rabbit
- 保质期:
12个月
- 抗体英文名:
Phospho-PPAR Gamma (ser273) antibody
- 抗体名:
磷酸化过氧化酶活化增生受体γ抗体 PPARγ
- 宿主:
Rabbit
- 适应物种:
Human, Mouse, Rat, Chicken, Pig, Cow, Rabbit, Sheep,
- 免疫原:
KLH conjugated synthesised phosphopeptide derived from human PPAR Gamma around the phosphorylation site of ser273:251-350/505
- 亚型:
IgG
- 形态:
冻干粉或液体
- 应用范围:
WB=1:500-2000 ELISA=1:500-1000 IHC-P=1:400-800 IHC-F=1:400-800 ICC=1:100-500 IF=1:100-500
- 浓度:
1mg/ml
- 保存条件:
-20 °C
- 规格:
100ul
| 中文名称 | 磷酸化过氧化酶活化增生受体γ抗体 PPARγ |
| 别 名 | Phospho-PPAR Gamma(ser273); P-PPAR Gamma (Phospho-ser273); CIMT1; HUMPPARG; NR1C3; Nuclear receptor subfamily 1 group C member 3; PAX8/PPARG Fusion Gene; Peroxisome Proliferator Activated Receptor gamma; PPAR gamma; PPARG; PPARG1; PPARG2; PPARG3; PPARG_HUMAN. |
![]() |
Specific References (10) | bs-4888R has been referenced in 10 publications. [IF=3.73] Kolli, Vipula, et al. "Partial Agonist, Telmisartan, Maintains PPARγ Serine 112 Phosphorylation, and Does Not Affect Osteoblast Differentiation and Bone Mass." PLOS ONE 9.5 (2014): e96323. WB ; Mouse. PubMed:24810249 [IF=1.29] Pandurangan, Muthuraman, Jeongeun Park, and Eunjung Kim. "Aspartame downregulates 3T3-L1 differentiation." In Vitro Cellular & Developmental Biology-Animal (2014): 1-7. WB ; Mouse. PubMed:24961835 [IF=5.08] Liu, Chang, et al. "Identification of a novel selective agonist of PPARγ with no promotion of adipogenesis and less inhibition of osteoblastogenesis." Scientific Reports 5 (2015). WB ; Mouse. PubMed:25827822 [IF=5.58] Agrawal, S., et al. "Pioglitazone Enhances the Beneficial Effects of Glucocorticoids in Experimental Nephrotic Syndrome." Scientific Reports 6 (2016): 24392. IHC-P ; Rat. PubMed:27142691 [IF=4.26] Stechschulte, Lance A., et al. "Protein Phosphatase PP5 Controls Bone Mass and the Negative Effects of Rosiglitazone on Bone through Reciprocal Regulation of PPARγ and RUNX2." Journal of Biological Chemistry (2016). WB ; Mouse. PubMed:27687725 [IF=4.26] Maganti, Aarthi V., et al. "Peroxisome Proliferator-Activated Receptor-γ Activation Augments the β Cell Unfolded Protein Response and Rescues Early Glycemic Deterioration and β Cell Death in Non-Obese Diabetic Mice."Journal of Biological Chemistry (2016): jbc-M116. WB ; Mouse. PubMed:27613867 [IF=4.26] Alla, Joshua Abd, et al. "Inhibition of G-protein-coupled Receptor Kinase 2 Prevents the Dysfunctional Cardiac Substrate Metabolism in Fatty Acid Synthase Transgenic Mice." Journal of Biological Chemistry 291.6 (2016): 2583-2600. WB ; Mouse. PubMed:26670611 [IF=3.86] Liu, Lei, et al. "Dihydromyricetin delays the onset of hyperglycemia and ameliorates insulin resistance without excessive weight gain in Zucker diabetic fatty rats." Molecular and Cellular Endocrinology (2016). WB ; Rat. PubMed:27984083 [IF=3.23] Sarr, Ousseynou, et al. "Low birth weight male guinea pig offspring display increased visceral adiposity in early adulthood." PloS one 9.6 (2014): e98433. WB ; Guinea Pig. PubMed:24926663 [IF=0.00] Yuan, Hai-Feng, et al. "Expression of p-PPARγ in the aging thoracic aorta of spontaneously hypertensive rat and inhibitory effect of rosiglitazone." Asian Pacific Journal of Tropical Biomedicine 4.12 (2014): 977-981. IHC-P ; Rat. PubMed:0 |
| 规格价格 | 100ul/1580元 购买 大包装/询价 |
| 说 明 书 | 100ul |
| 产品类型 | 磷酸化抗体 |
| 研究领域 | 肿瘤 细胞生物 信号转导 细胞凋亡 激酶和磷酸酶 表观遗传学 |
| 抗体来源 | Rabbit |
| 克隆类型 | Polyclonal |
| 交叉反应 | Human, Mouse, Rat, Chicken, Pig, Cow, Rabbit, Sheep, |
| 产品应用 | WB=1:500-2000 ELISA=1:500-1000 IHC-P=1:400-800 IHC-F=1:400-800 ICC=1:100-500 IF=1:100-500 (石蜡切片需做抗原修复) not yet tested in other applications. optimal dilutions/concentrations should be determined by the end user. |
| 分 子 量 | 57kDa |
| 细胞定位 | 细胞核 细胞浆 |
| 性 状 | Lyophilized or Liquid |
| 浓 度 | 1mg/ml |
| 免 疫 原 | KLH conjugated synthesised phosphopeptide derived from human PPAR Gamma around the phosphorylation site of ser273:251-350/505 |
| 亚 型 | IgG |
| 纯化方法 | affinity purified by Protein A |
| 储 存 液 | 0.01M TBS(pH7.4) with 1% BSA, 0.03% Proclin300 and 50% Glycerol. |
| 保存条件 | Store at -20 °C for one year. Avoid repeated freeze/thaw cycles. The lyophilized antibody is stable at room temperature for at least one month and for greater than a year when kept at -20°C. When reconstituted in sterile pH 7.4 0.01M PBS or diluent of antibody the antibody is stable for at least two weeks at 2-4 °C. |
| PubMed | PubMed |
| 产品介绍 | background: This gene encodes a member of the peroxisome proliferator-activated receptor (PPAR) subfamily of nuclear receptors. PPARs form heterodimers with retinoid X receptors (RXRs) and these heterodimers regulate transcription of various genes. Three subtypes of PPARs are known: PPAR-alpha, PPAR-delta, and PPAR-gamma. The protein encoded by this gene is PPAR-gamma and is a regulator of adipocyte differentiation. Additionally, PPAR-gamma has been implicated in the pathology of numerous diseases including obesity, diabetes, atherosclerosis and cancer. Alternatively spliced transcript variants that encode different isoforms have been described. Function: Receptor that binds peroxisome proliferators such as hypolipidemic drugs and fatty acids. Once activated by a ligand, the receptor binds to a promoter element in the gene for acyl-CoA oxidase and activates its transcription. It therefore controls the peroxisomal beta-oxidation pathway of fatty acids. Key regulator of adipocyte differentiation and glucose homeostasis. Subunit: Forms a heterodimer with the retinoic acid receptor RXRA called adipocyte-specific transcription factor ARF6. Interacts with NCOA6 coactivator, leading to a strong increase in transcription of target genes. Interacts with coactivator PPARBP, leading to a mild increase in transcription of target genes. Interacts with FAM120B. Interacts with PRDM16 (By similarity). Interacts with NOCA7 in a ligand-inducible manner. Interacts with NCOA1 LXXLL motifs. Interacts with DNTTIP2, MAP2K1/MEK1, PRMT2 and TGFB1I1. Interacts with PDPK1. Interacts with ASXL1 AND ASXL2. Subcellular Location: Nucleus. Cytoplasm. Tissue Specificity: Highest expression in adipose tissue. Lower in skeletal muscle, spleen, heart and liver. Also detectable in placenta, lung and ovary. DISEASE: Note=Defects in PPARG can lead to type 2 insulin-resistant diabetes and hyptertension. PPARG mutations may be associated with colon cancer. Defects in PPARG may be associated with susceptibility to obesity (OBESITY) [MIM:601665]. It is a condition characterized by an increase of body weight beyond the limitation of skeletal and physical requirements, as the result of excessive accumulation of body fat. Defects in PPARG are the cause of familial partial lipodystrophy type 3 (FPLD3) [MIM:604367]. Familial partial lipodystrophies (FPLD) are a heterogeneous group of genetic disorders characterized by marked loss of subcutaneous (sc) fat from the extremities. Affected individuals show an increased preponderance of insulin resistance, diabetes mellitus and dyslipidemia. Genetic variations in PPARG can be associated with susceptibility to glioma type 1 (GLM1) [MIM:137800]. Gliomas are central nervous system neoplasms derived from glial cells and comprise astrocytomas, glioblastoma multiforme, oligodendrogliomas, and ependymomas. Note=Polymorphic PPARG alleles have been found to be significantly over-represented among a cohort of American patients with sporadic glioblastoma multiforme suggesting a possible contribution to disease susceptibility. Similarity: Belongs to the nuclear hormone receptor family. NR1 subfamily. Contains 1 nuclear receptor DNA-binding domain. SWISS: P37231 Gene ID: 5468 Database links: Entrez Gene: 5468 Human Entrez Gene: 19016 Mouse Entrez Gene: 25664 Rat SwissProt: P37231 Human SwissProt: P37238 Mouse SwissProt: O88275 Rat Unigene: 162646 Human Unigene: 3020 Mouse Unigene: 23443 Rat Important Note: This product as supplied is intended for research use only, not for use in human, therapeutic or diagnostic applications. |
| 产品图片 | ![]() Sample: HepG2 Cell (Human) Lysate at 30 ug Primary: Anti-p-PPAR Gamma (ser273) (bs-4888R)at 1/300 dilution Secondary: IRDye800CW Goat Anti-Rabbit IgG at 1/20000 dilution Predicted band size: 57kD Observed band size: 55kD ![]() Sample: Placenta (Mouse) Lysate at 40 ug Primary: Anti-Phospho-PPAR Gamma (ser273) (bs-4888R) at 1/300 dilution Secondary: IRDye800CW Goat Anti-Rabbit IgG at 1/20000 dilution Predicted band size: 57 kD Observed band size: 57 kD ![]() Sample: A549 Cell (Human) Lysate at 30 ug Primary: Anti-Phospho-PPAR Gamma (ser273) (bs- 4888R) at 1/300 dilution Secondary: IRDye800CW Goat Anti-Rabbit IgG at 1/20000 dilution Predicted band size: 57 kD Observed band size: 57 kD ![]() Tissue/cell: human lung carcinoma; 4% Paraformaldehyde-fixed and paraffin-embedded; Antigen retrieval: citrate buffer ( 0.01M, pH 6.0 ), Boiling bathing for 15min; Block endogenous peroxidase by 3% Hydrogen peroxide for 30min; Blocking buffer (normal goat serum,C-0005) at 37℃ for 20 min; Incubation: Anti-Phospho-PPAR Gamma(ser273) Polyclonal Antibody, Unconjugated(bs-4888R) 1:200, overnight at 4°C, followed by conjugation to the secondary antibody(SP-0023) and DAB(C-0010) staining ![]() Tissue/cell: human gastric carcinoma; 4% Paraformaldehyde-fixed and paraffin-embedded; Antigen retrieval: citrate buffer ( 0.01M, pH 6.0 ), Boiling bathing for 15min; Block endogenous peroxidase by 3% Hydrogen peroxide for 30min; Blocking buffer (normal goat serum,C-0005) at 37℃ for 20 min; Incubation: Anti-Phospho-PPAR Gamma(ser273) Polyclonal Antibody, Unconjugated(bs-4888R) 1:200, overnight at 4°C, followed by conjugation to the secondary antibody(SP-0023) and DAB(C-0010) staining ![]() phosphopeptide non phosphopeptide |
风险提示:丁香通仅作为第三方平台,为商家信息发布提供平台空间。用户咨询产品时请注意保护个人信息及财产安全,合理判断,谨慎选购商品,商家和用户对交易行为负责。对于医疗器械类产品,请先查证核实企业经营资质和医疗器械产品注册证情况。
文献和实验Using Phospho‐Motif Antibodies to Determine Kinase Substrates
comprising both the phosphorylated residue and the surrounding residues that determine kinase specificity, with degenerate residues taking up the remaining positions. Currently, several categories of phospho?motif antibody are commercially available
Adipose Tissue-Specific PPAR Gene Targeting
The nuclear receptor peroxisome proliferator activated receptor gamma (PPARγ) is most abundantly expressed in adipose tissue and has been shown to play imperative roles in controlling adipogenesis and lipogenesis in cultured
Optimized Protocol to Make Phospho-Specific Antibodies that Work
, not simply its level of expression. In this review, we will discuss both the design of the phosphopeptide immunogen and immunization. The affinity purification of the phospho-specific antibody as well as the methods most suitable for characterizing
技术资料暂无技术资料 索取技术资料